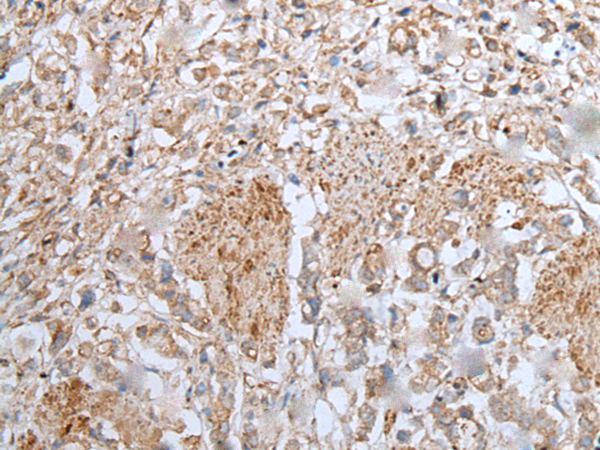

中文名稱:兔抗UBA6多克隆抗體
|
Background: |
Modification of proteins with ubiquitin (UBB; MIM 191339) or ubiquitin-like proteins controls many signaling networks and requires a ubiquitin-activating enzyme (E1), a ubiquitin conjugating enzyme (E2), and a ubiquitin protein ligase (E3). UBE1L2 is an E1 enzyme that initiates the activation and conjugation of ubiquitin-like proteins (Jin et al., 2007 [PubMed 17597759]). |
|
Applications: |
ELISA, IHC |
|
Name of antibody: |
UBA6 |
|
Immunogen: |
Fusion protein of human UBA6 |
|
Full name: |
ubiquitin-like modifier activating enzyme 6 |
|
Synonyms: |
E1-L2; MOP-4; UBE1L2 |
|
SwissProt: |
A0AVT1 |
|
ELISA Recommended dilution: |
5000-10000 |
|
IHC positive control: |
Human cervical cancer and human thyroid cancer |
|
IHC Recommend dilution: |
25-100 |

購物車
幫助
021-54845833/15800441009
